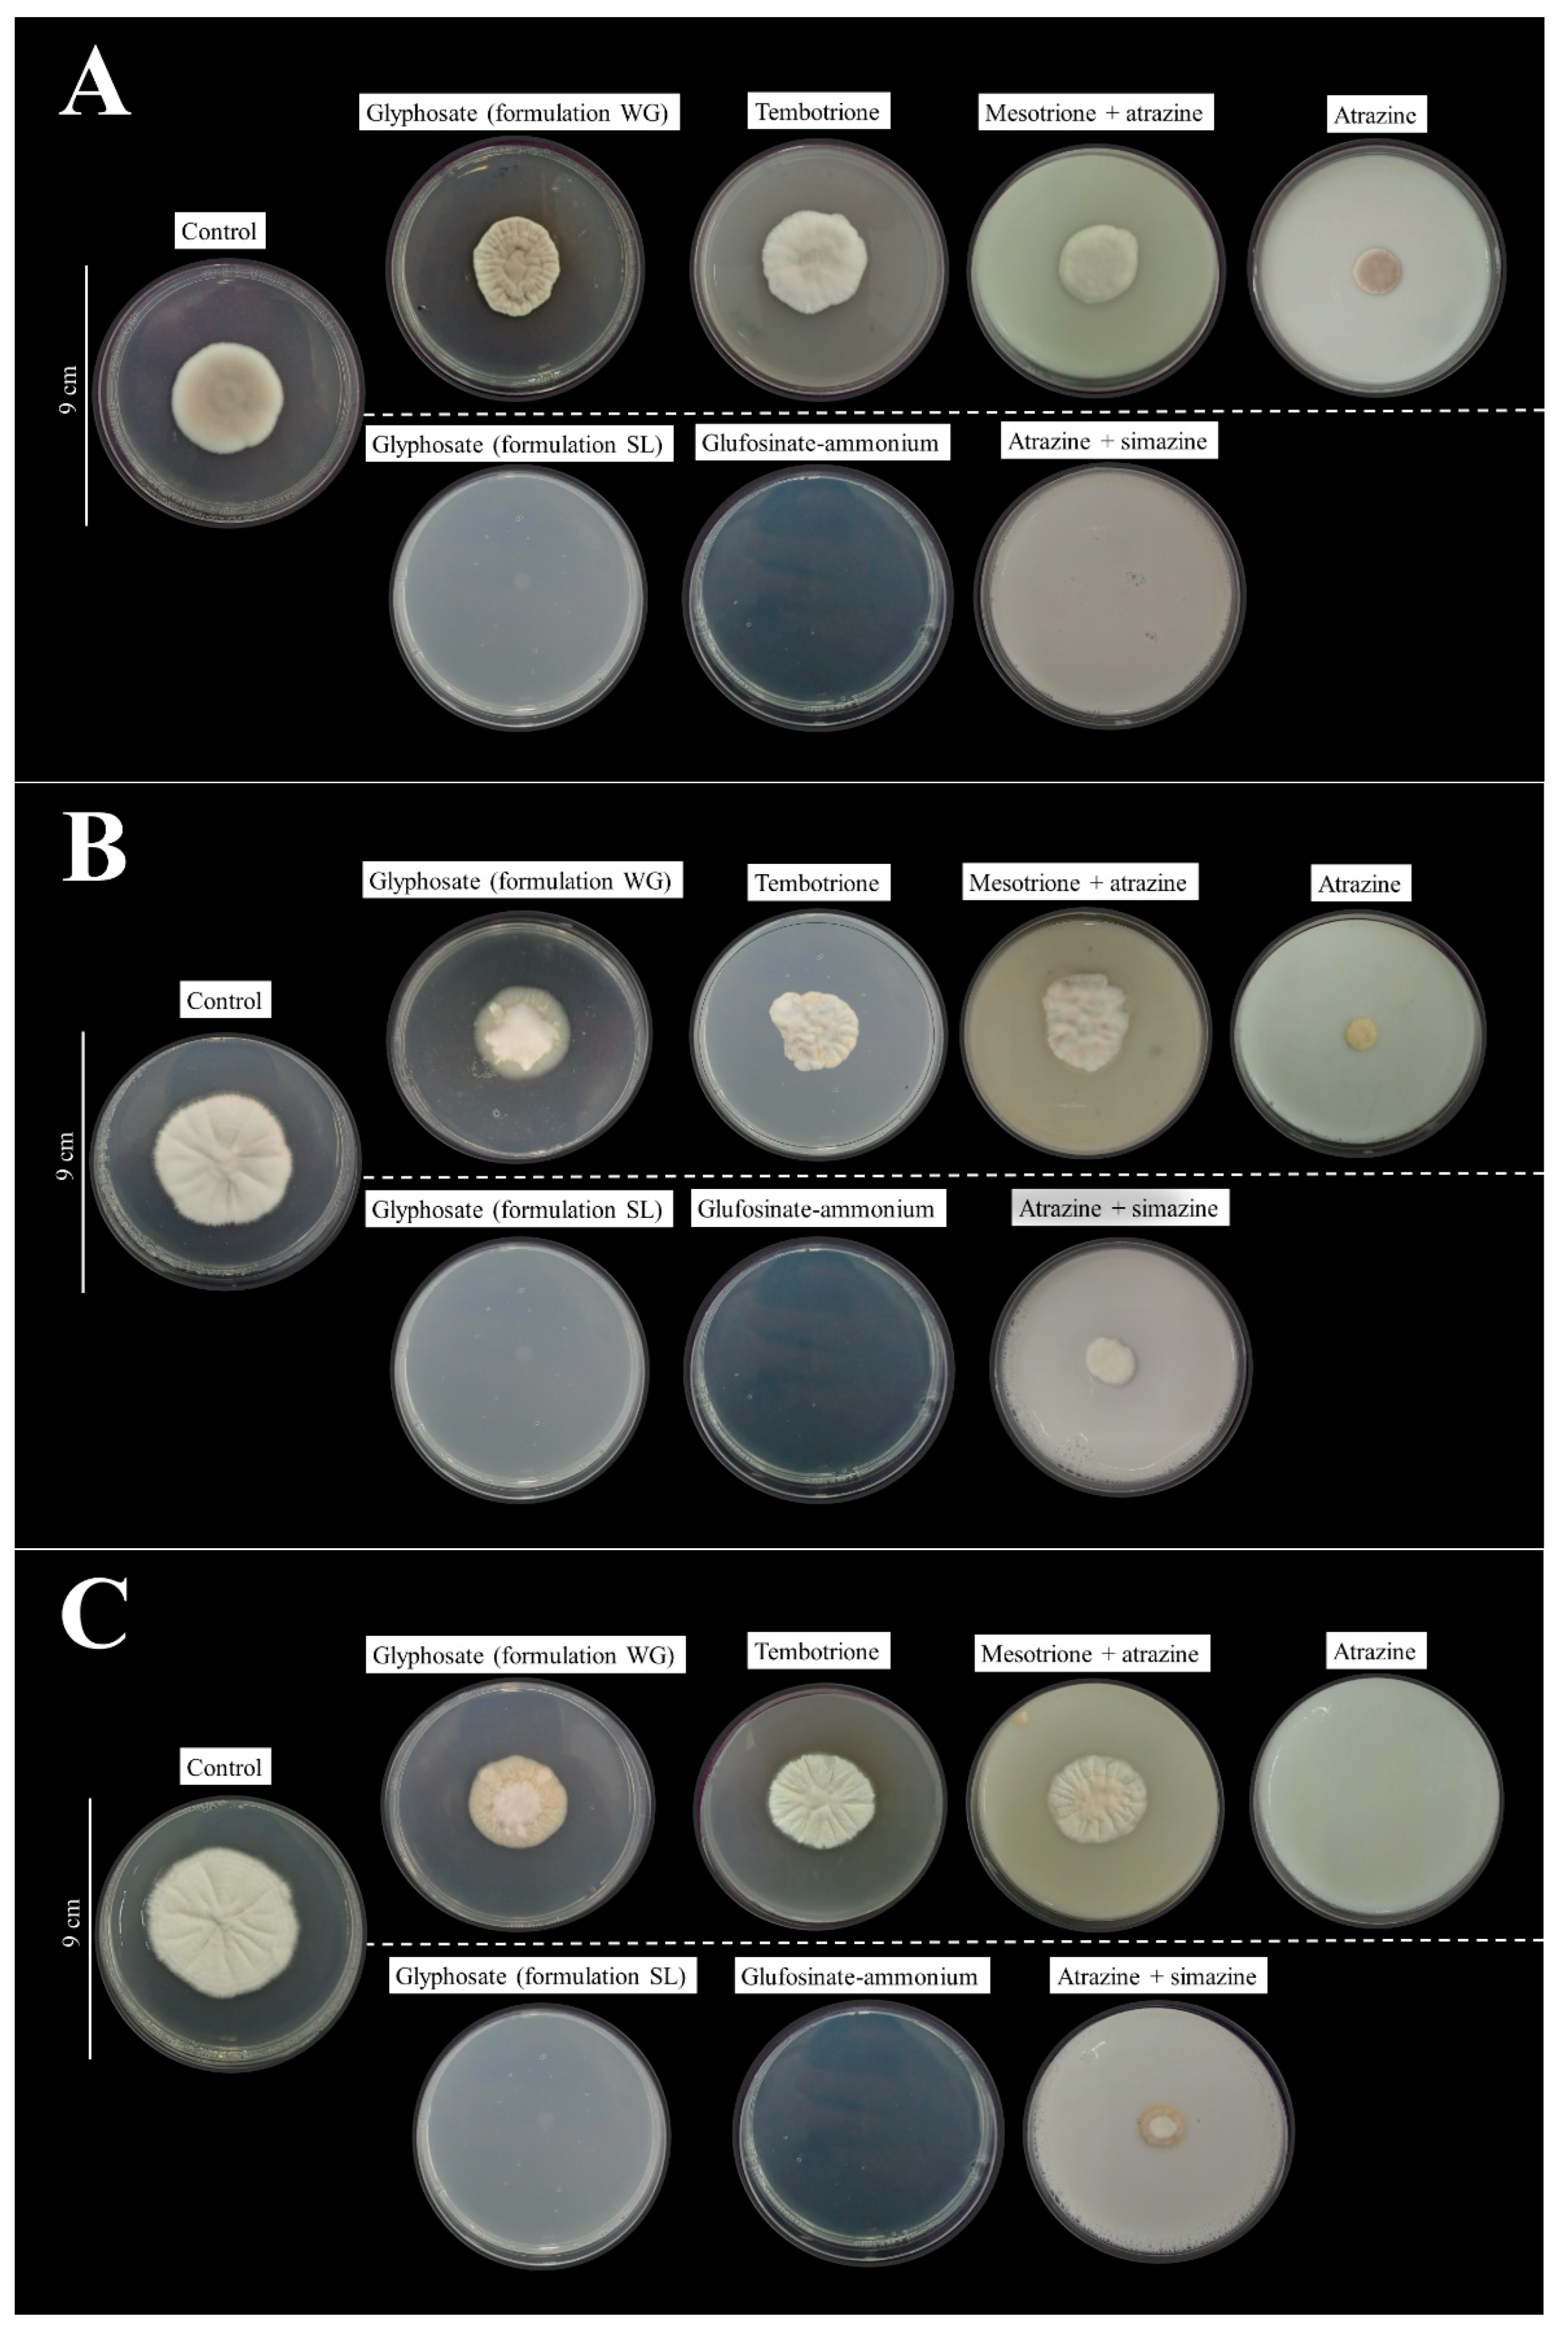
Agriculture 14 02189 g001

Toxicity of Post-Emergent Herbicides on Entomopathogenic Fungi Used in the Management of Corn Leafhopper: In Vitro and In Vivo Assessments
Abstract
1. Introduction
2. Materials and Methods
2.1. Herbicides and Mycoinsecticides
2.2. Tested Insects
2.3. Obtaining and Propagating Entomopathogenic Fungal Isolates
2.4. In Vitro Bioassays
2.4.1. Effects of Herbicides on Colony-Forming Units (CFU) of Pure Isolates of Entomopathogenic Fungi
2.4.2. Vegetative Growth of Fungal Isolates Exposed to Herbicide-Treated Culture Media
2.4.3. Conidial Production and Viability of Fungal Isolates Exposed to Herbicide-Treated Culture Media
2.4.4. Determination of Compatibility Between Herbicides and Pure Entomopathogenic Fungi
2.5. Physicochemical Analysis
2.6. Effects of Herbicides on the CFU of Mycoinsecticide Commercial Formulations
2.7. Comparison of the Reduction in the Number of CFU of Pure and Formulated Spores (OD and SC Formulations) When Mixed with Herbicides
2.8. In Vivo Bioassays
2.9. Data Analysis
3. Results
3.1. In Vitro Compatibility
3.1.1. Effects of Herbicides on Colony-Forming Units (CFU) of Entomopathogenic Fungi Pure Isolates
3.1.2. Vegetative Growth of Fungal Isolates Exposed to Herbicides-Treated Culture Media
3.1.3. Conidial Production and Viability of Fungal Isolates Exposed to Herbicide-Treated Culture Media
3.1.4. Determination of Compatibility Between Herbicides and Pure Isolates of Entomopathogenic Fungi
3.2. Physicochemical Analysis
3.3. Effects of Herbicides on CFU of Mycoinsecticide Commercial Formulations
3.4. Comparison of the Reduction in CFU Number of Fungi Isolates and Their Respective Commercial Formulations When Mixed with Synthetic Herbicides
3.5. In Vivo Bioassays
4. Discussion
5. Conclusions
Supplementary Materials
Author Contributions
Funding
Institutional Review Board Statement
Informed Consent Statement
Data Availability Statement
Conflicts of Interest
References
- Soltani, N.; Dille, J.A.; Burke, I.C.; Everman, W.J.; VanGessel, M.J.; Davis, V.M.; Sikkema, P.H. Potential corn yield losses from weeds in North America. Weed Technol. 2016, 30, 979–984. [Google Scholar] [CrossRef]
- López-Ovejero, R.F.; Fancelli, A.L.; Dourado-Neto, D.; García, A.G.; Christoffoleti, P.J. Selectivity to corn crop (Zea mays) of herbicides applied in different crop phenological stages. Planta Daninha 2003, 21, 413–419. [Google Scholar] [CrossRef]
- Frandoloso, F.S.; Galon, L.; Concenço, G.; Rossetto, E.R.O.; Bianchessi, F.; Santin, C.O.; Forte, C.T. Interference and level of economic damage of alexandergrass on corn. Planta Daninha 2020, 38, e020219966. [Google Scholar] [CrossRef]
- Stephenson, D.O.; Bond, J.A.; Landry, R.L.; Edwards, H.M. Weed management in corn with post-emergence applications of tembotrione or thiencarbazone: Tembotrione. Weed Technol. 2017, 29, 350–358. [Google Scholar] [CrossRef]
- Swinton, S.M.; Van Deynze, B. Hoes to herbicides: Economics of evolving weed management in the United States. Eur. J. Dev. Res. 2017, 29, 560–574. [Google Scholar] [CrossRef]
- Overton, K.; Maino, J.L.; Day, R.; Umina, P.A.; Bett, B.; Carnovale, D.; Ekesi, S.; Meagher, R.; Reynolds, O.L. Global crop impacts, yield losses and action thresholds for fall armyworm (Spodoptera frugiperda): A review. Crop Prot. 2021, 145, e105641. [Google Scholar] [CrossRef]
- Silva, P.R.; Istchuk, A.N.; Foresti, J.; Hunt, T.E.; Araújo, T.A.; Fernandes, F.L.; Alencar, E.R.; Bastos, C.S. Economic injury levels and economic thresholds for Diceraeus (Dichelops) melacanthus (Hemiptera: Pentatomidae) in vegetative maize. Crop Prot. 2021, 143, e105476. [Google Scholar] [CrossRef]
- Oliveira, C.M.; Frizzas, M.R. Eight decades of Dalbulus maidis (DeLong & Wolcott) (Hemiptera, Cicadellidae) in Brazil: What we know and what we need to know. Neotrop. Entomol. 2022, 51, 1–17. [Google Scholar] [CrossRef]
- Gazziero, D.L.P. Mixtures of pesticides in tank, in Brazilian farms. Planta Daninha 2015, 33, 83–92. [Google Scholar] [CrossRef]
- Gandini, E.M.M.; Costa, E.S.P.; Santos, J.B.; Soares, M.A.; Barroso, G.M.; Corrêa, J.M.; Zanuncio, J.C. Compatibility of pesticides and/or fertilizers in tank mixtures. J. Clean. Prod. 2020, 268, e122152. [Google Scholar] [CrossRef]
- Petter, F.A.; Segate, D.; Pacheco, L.P.; Almeida, F.A.; Alcântara-Neto, F. Physical incompatibility of herbicide and insecticide mixtures. Planta Daninha 2012, 30, 449–457. [Google Scholar] [CrossRef]
- Rajula, J.; Karthi, S.; Mumba, S.; Pittarate, S.; Thungrabeab, M.; Krutmuang, P. Current status and future prospects of entomopathogenic fungi: A potential source of biopesticides. Recent Adv. Microb. Biotechnol. 2021, 4, 71–98. [Google Scholar] [CrossRef]
- Sharma, A.; Sharma, S.; Yadav, P.K. Entomopathogenic fungi and their relevance in sustainable agriculture: A review. Cogent. Food Agric. 2023, 9, 2180857. [Google Scholar] [CrossRef]
- Moussa, A.; Maixner, M.; Stephan, D.; Santoiemma, G.; Passera, A.; Mori, N.; Quaglino, F. Entomopathogenic nematodes and fungi to control Hyalesthes obsoletus (Hemiptera: Auchenorrhyncha: Cixiidae). BioControl 2021, 66, 523–534. [Google Scholar] [CrossRef]
- Xia, Y.; Yu, S.; Yang, Q.; Shang, J.; He, Y.; Song, F.; Jiang, C. Sublethal effects of Beauveria bassiana Strain BEdy1 on the development and reproduction of the white-backed planthopper, Sogatella furcifera (Horváth) (Hemiptera: Delphacidae). J. Fungi 2023, 9, 123. [Google Scholar] [CrossRef]
- Ting-ting, Z.; Qian, Z.; Cheng-zhou, L.I.; Lu, Y.E.; Yan-fang, L.I.; Keyhani, N.O.; Zhen, H. Synergistic effects of the entomopathogenic fungus Isaria fumosorosea and low doses of dinotefuran on the efficient control of the rice pest Sogatella furcifera. J. Integ. Agric. 2024, 2, 621–638. [Google Scholar] [CrossRef]
- Parra, J.R.P. Controle biológico na agricultura brasileira. Entomol. Commun. 2019, 1, ec01002. [Google Scholar] [CrossRef]
- Parra, J.R.P. Biological control in Brazil: State of art and perspectives. Sci. Agric. 2023, 80, e20230080. [Google Scholar] [CrossRef]
- Pozebon, H.; Stürmer, G.R.; Arnemann, J.A. Corn stunt pathosystem and its leafhopper vector in Brazil. J. Econ. Entomol. 2022, 115, 1817–1833. [Google Scholar] [CrossRef]
- Ribeiro, L.P.; Telles, D.T.; Rakes, M.; Belegante, F.; Moresco, C.; Nesi, C.N.; Zanardi, A.M.; Grützmacher, A.D.; Bernardi, D.; Zanardi, O.Z. Insecticides for corn leafhopper management versus entomopathogenic fungal isolates: In vitro compatibility, physical-chemical interactions, and on-farm assessments. Crop Prot. 2023, 174, e106417. [Google Scholar] [CrossRef]
- Virla, E.G.; Araoz, M.C.; Albarracin, E.L. Estimation of direct damage to maize seedlings by the corn leafhopper, Dalbulus maidis (Hemiptera: Cicadellidae), under different watering regimes. Bull. Entomol. Res. 2021, 111, 438–444. [Google Scholar] [CrossRef] [PubMed]
- Galvão, S.R.; Sabato, E.O.; Bedendo, I.P. Occurrence and distribution of single or mixed infection of phytoplasma and spiroplasma causing corn stunting in Brazil. Trop. Plant Pathol. 2021, 46, 152–155. [Google Scholar] [CrossRef]
- Albuquerque, M.R.M.; Amaral, D.S.; Nascimento, S.C.; Santos, A.N.M.R.; Gorayeb, E.; Hora Júnior, B.T.; Camargo, M.P.; Bellini, L.F.; Schuster, I.M.; Mendes, G.C.; et al. First report of maize rayado fino virus in corn fields in Santa Catarina, Brazil. Plant Dis. 2022, 107, 590–591. [Google Scholar] [CrossRef] [PubMed]
- Vilanova, E.S.; Ramos, A.; Oliveira, M.C.S.; Esteves, M.B.; Gonçalves, M.C.; Lopes, J.R. First report of a mastrevirus (Geminiviridae) transmitted by the corn leafhopper. Plant Disease 2022, 106, 1330–1333. [Google Scholar] [CrossRef]
- Ribeiro, L.P.; Canale, M.C. Cigarrinha-do-milho e o complexo de enfezamentos em Santa Catarina: Panorama, patossistema e estratégias de manejo. Agropecuária Catarin. 2021, 34, 22–25. [Google Scholar] [CrossRef]
- Agrofit. Sistema de Agrotóxicos Fitossanitários, Ministério da Agricultura, Pecuária e Abastecimento. 2024. Available online: http://agrofit.agricultura.gov.br/agrofit_cons/principal_agrofit_cons (accessed on 10 January 2024).
- Lopes, R.B.; Pauli, G.; Mascarin, G.M.; Faria, M. Protection of entomopathogenic conidia against chemical fungicides afforded by an oil-based formulation. Bio. Sci. Technol. 2010, 21, 125–137. [Google Scholar] [CrossRef]
- Rakes, M.; Grutzmacher, A.D.; Pazini, J.B.; Pasini, R.A.; Schaedler, C.E. Physicochemical compatibility of agrochemical mixtures in spray tanks for paddy field rice crops. Planta Daninha 2018, 35, e017165185. [Google Scholar] [CrossRef]
- Vommaro, M.L.; Zanchi, C.; Angelone, T.; Giglio, A.; Kurtz, J. Herbicide exposure alters the effect of the enthomopathogen Beauveria bassiana on immune gene expression in mealworm beetles. Environ. Poll. 2023, 338, 122662. [Google Scholar] [CrossRef]
- Hanway, J.J. Growth stages of corn (Zea mays, L.). Agron. J. 1963, 55, 487–492. [Google Scholar] [CrossRef]
- Coremans-Pelseneer, J. Laboratory tests on the entomopathogenic fungus Beauveria. IOBC/WPRS Bull. 1994, 17, 147–155. [Google Scholar]
- Rossi-Zalaf, L.S.; Alves, S.B.; Lopes, R.B.; Silveira Neto, S.; Tanzini, M.R. Microorganism interaction with other pest and disease control agents. In Microbial Control of Pest in Latin America: Advances and Challenges; Alves, S.B., Lopes, R.B., Eds.; Fealq: Piracicaba, Brazil, 2008; pp. 279–302. [Google Scholar]
- NBR 13875:2014; Agrotóxicos e Afins—Avaliação de Compatibilidade Físico-Química. Associação Brasileira de Normas Técnicas (ABNT): Rio de Janeiro, Brazil, 2014; pp. 1–12.
- NBR NM ISO 3310-1:2010; Peneiras de Ensaio—Requisitos Técnicos e Verificação. Parte 1: Peneiras de Ensaio com tela de Tecido Metálico. Associação Brasileira de Normas Técnicas (ABNT): Rio de Janeiro, Brazil, 2010; pp. 1–20.
- Candolfi, M.P.; Blümel, S.; Forster, R.; Bakker, F.M.; Grimm, C.; Hassan, S.A.; Heimbach, U.; Mead-Briggs, M.A.; Reber, B.; Schmuck, R.; et al. Guidelines to Evaluate Side-Effects of Plant Protection Products to Non-Target Arthropods; International Organization for Biological and Integrated Control of Noxious Animals and Weeds, West Palearctic Regional Section (IOBC/WPRS): Gent Belgium, 2000. [Google Scholar]
- Barnett, H.L.; Hunter, B.B. Illustrated Genera of Imperfect Fungi; Burgess Publishing Company: Saint Paul, MN, USA, 1972. [Google Scholar]
- Bartlett, M.S. Properties of sufficiency and statistical tests. Proc. R. Soc. Ser. A 1937, 160, 268–282. [Google Scholar] [CrossRef]
- Box, G.E.P.; Cox, D.R. An analysis of transformations (with discussion). J. R. Stat. Soc. B Stat. Methodol. 1964, 26, 211–243. [Google Scholar] [CrossRef]
- Nelder, J.A.; Wedderburn, R.W.M. Generalized linear models. J. R. Stat. Soc. 1972, 135, 370–384. [Google Scholar] [CrossRef]
- Moral, R.A.; Hinde, J.; Demétrio, C.G.B. Half-normal plots and overdispersed models in R: The hnp package. J. Stat. Softw. 2017, 81, 1–23. [Google Scholar] [CrossRef]
- Hothorn, T.; Bretz, F.; Westfall, P. Simultaneous inference in general parametric models. Biom. J. 2008, 50, 346–363. [Google Scholar] [CrossRef]
- R Core Team. R—A Language and Environment for Statistical Computing; Version 3.6.2; R Core Team: Vienna, Austria, 2021; Available online: http://r-project.org (accessed on 9 June 2023).
- Silva, L.; Faria, A.F.; Guimarães, R.A.; Afridi, M.S.; Medeiros, F.H.V.; Medeiros, F.C.L. How can an in vitro incompatibility of Trichoderma-based products and herbicides impact the parasitism and control of white mold (Sclerotinia sclerotiorum (Lib.) De Bary)? J. Crop Health 2024, 2, 1–16. [Google Scholar] [CrossRef]
- Schumacher, V.; Poehling, H.M. In vitro effect of pesticides on the germination, vegetative growth, and conidial production of two strains of Metarhizium anisopliae. Fungal Biol. 2012, 116, 121–132. [Google Scholar] [CrossRef]
- Ribeiro, L.P.; Mota, L.H.C.; D’Alessandro, C.P.; Vendramim, J.D.; Delalibera, I. In vitro compatibility of an acetogenin-based bioinsecticide with three species of entomopathogenic fungi. Fla. Entomol. 2014, 97, 1395–1403. [Google Scholar] [CrossRef]
- Neto, R.A.; Melo, A.A.; Ulguim, A.D.R.; Pedroso, R.M.; Barbieri, G.F.; Luchese, E.F.; Leichtweiss, E.M. Mixtures of 2,4-D and dicamba with other pesticides and their influence on application parameters. Int. J. Pest Manag. 2021, 70, 121–130. [Google Scholar] [CrossRef]
- Li, J.; Chen, W.; Xu, Y.; Wu, X. Comparative effects of different types of tank-mixed adjuvants on the efficacy, absorption and translocation of cyhalofop-butyl in barnyardgrass (Echinochloa crus-galli [L.] Beauv.). Weed Biol. Manag. 2016, 16, 80–89. [Google Scholar] [CrossRef]
- Ferreira, P.H.U.; Thiesen, L.V.; Pelegrini, G.; Ramos, M.F.T.; Pinto, M.M.D.; Costa-Ferreira, M. Physicochemical properties, droplet size and volatility of dicamba with herbicides and adjuvants on tank-mixture. Sci. Rep. 2020, 10, 18833. [Google Scholar] [CrossRef] [PubMed]
- Ramos-Barrado, J.; Benavente, J.; Heredia, A. Electrical conductivity of differently treated isolated cuticular membranes by impedance spectroscopy. Arch. Biochem. 1993, 306, 337–341. [Google Scholar] [CrossRef] [PubMed]
- Tavares, R.M.; Cunha, J.P.A.R.D. Pesticide and adjuvant mixture impacts on the physical–chemical properties, droplet spectrum, and absorption of spray applied in soybean crop. AgriEngineering 2023, 5, 646–659. [Google Scholar] [CrossRef]
- Gardner, W.A.; Storey, G.K. Sensitivity of Beauveria bassiana to selected herbicides. J. Econ. Entomol. 1985, 78, 1275–1279. [Google Scholar] [CrossRef]
- Todorova, S.I.; Coderre, D.; Duchesne, R.M.; Côté, J.C. Compatibility of Beauveria bassiana with selected fungicides and herbicides. Environ. Entomol. 1998, 27, 427–433. [Google Scholar] [CrossRef]
- Avery, P.B.; Pick, D.A.; Aristizábal, L.F.; Kerrigan, J.; Powell, C.A.; Rogers, M.E.; Arthurs, S.P. Compatibility of Isaria javanica (Hypocreales: Cordycipitaceae) blastospores with agricultural chemicals used for management of the Asian citrus psyllid, Diaphorina citri (Hemiptera: Liviidae). Insects 2013, 4, 694–711. [Google Scholar] [CrossRef]
- Khun, K.K.; Ash, G.J.; Stevens, M.M.; Huwere, R.K.; Wilson, B.A.L. Compatibility of Metarhizium anisopliae and Beauveria bassiana with insecticides and fungicides used in macadamia production in Australia. Pest Manag. Sci. 2020, 77, 709–718. [Google Scholar] [CrossRef]
- Morjan, W.E.; Pedigo, L.P.; Lewis, L.C. Fungicidal effects of glyphosate and glyphosate formulations on four species of entomopathogenic fungi. Environ. Entomol. 2002, 31, 1206–1212. [Google Scholar] [CrossRef]
- Diao, H.; Tian, J.; Xing, P.; Han, Z.; Liu, T. Evaluation of the compatibility of Isaria fumosorosea (Hypocreales: Cordycipitaceae) IF-1106 with several adjuvants. Biocontrol Sci. Technol. 2021, 31, 512–525. [Google Scholar] [CrossRef]
- Grewal, G.K.; Joshi, N. Evaluation of adjuvants on growth and virulence of Metarhizium rileyi against Spodoptera litura (F.). Indian J. Entomol. 2022, 85, 997–1000. [Google Scholar] [CrossRef]
- Mascarin, G.M.; Jaronski, S.T. The production and uses of Beauveria bassiana as a microbial insecticide. World J. Microbiol. Biotechnol. 2016, 32, 1–26. [Google Scholar] [CrossRef] [PubMed]
- Behle, R.; Birthisel, T. Formulations of entomopathogens as bioinsecticides. In Mass Production of Beneficial Organisms, 2nd ed.; Morales-Ramos, J.A., Rojas, M.G., Shapiro-Ilan, D.I., Eds.; Academic Press: Cambridge, MA, USA, 2023; pp. 407–429. [Google Scholar] [CrossRef]
- Yiğit, A.U. Auto-dissemination of Cordyceps fumosorosea amongst adult females of the two-spotted spider mite. Exp. Appl. Acarol. 2023, 91, 279–290. [Google Scholar] [CrossRef] [PubMed]
- Qayyum, M.A.; Saleem, M.A.; Saeed, S.; Wakil, W.; Ishtiaq, M.; Ashraf, W.; Ahmed, N.; Ali, M.; Ikram, R.M.; Yasin, M.; et al. Integration of entomopathogenic fungi and eco-friendly insecticides for management of red palm weevil, Rhynchophorus ferrugineus (Olivier). Saudi J. Biol. Sci. 2020, 27, 1811–1817. [Google Scholar] [CrossRef]
- Nawaz, A.; Razzaq, F.; Razzaq, A.; Gogi, M.D.; Fernández-Grandon, G.M.; Tayib, M.; Ayub, M.A.; Sufyan, M.; Shadid, M.R.; Qayyum, M.A.; et al. Compatibility and synergistic interactions of fungi, Metarhizium anisopliae, and insecticide combinations against the cotton aphid, Aphis gossypii Glover (Hemiptera: Aphididae). Sci. Rep. 2022, 12, 4843. [Google Scholar] [CrossRef]
- Bevilaqua, J.G.; Padilha, G.; Pozebon, H.; Marques, R.P.; Cargnelutti Filho, A.; Ramon, P.C.; Boeni, L.; Castilhos, L.B.; Luz, G.R.; Brum, A.L.S.S.; et al. A sustainable approach to control whitefly on soybean: Integrating entomopathogenic fungi with insecticides. Crop Prot. 2023, 164, 106145. [Google Scholar] [CrossRef]
- Ortiz-Urquizam, A.; Keyhani, N.O. Action on the surface: Entomopathogenic fungi versus the insect cuticle. Insects 2013, 4, 357–374. [Google Scholar] [CrossRef]
- Jarrold, S.L.; Moore, D.; Potter, U.; Charnley, A.K. The contribution of surface waxes to pre-penetration growth of an entomopathogenic fungus on host cuticle. Mycol. Res. 2007, 111, 240–249. [Google Scholar] [CrossRef]
- Islam, W.; Adnan, M.; Shabbir, A.; Naveed, H.; Abubakar, Y.S.; Qasim, M.; Ali, H. Insect-fungal-interactions: A detailed review on entomopathogenic fungi pathogenicity to combat insect pests. Microb. Pathog. 2021, 159, 105122. [Google Scholar] [CrossRef]
- Balabanidou, V.; Grigoraki, L.; Vontas, J. Insect cuticle: A critical determinant of insecticide resistance. Curr. Opin. Insect Sci. 2018, 27, 68–74. [Google Scholar] [CrossRef]
- Taylor, R.A.J.; Nault, L.R.; Styer, W.E. Experimental analysis of flight activity of three Dalbulus leafhoppers (Homoptera: Auchenorrhyncha) in relation to migration. Ann. Entomol. Soc. Am. 1993, 86, 655–667. [Google Scholar] [CrossRef]

| Pesticides (Concentration g L−1 or g kg−1) | Commercial Brands | Formulation 1 | Tested Dose 2 (mL or g ha−1) | Manufacturer |
|---|---|---|---|---|
| Synthetic Herbicides | ||||
| Glyphosate (577.0) | Roundup Original Mais® | SL | 6000.0 | Bayer S/A (São José dos Campos, São Paulo, Brazil) |
| Glyphosate (792.5) | Roundup WG® | WG | 3500.0 | Bayer S/A (São José dos Campos, São Paulo, Brazil) |
| Glufosinate–ammonium (200.0) | Finale® | SL | 2000.0 | Basf SE (Guaratinguetá, São Paulo, Brazil) |
| Atrazine (400.0) | Primóleo® | SC | 6000.0 | Syngenta Proteção de Cultivos Ltda. (Paulínia, São Paulo, Brazil) |
| Tembotrione (420.0) | Soberan® | SC | 240.0 | Bayer S/A (São José dos Campos, São Paulo, Brazil) |
| Atrazine + simazine (250.0 + 250.0) | Primatop SC® | SC | 8000.0 | Syngenta Proteção de Cultivos Ltda. (Paulínia, São Paulo, Brazil) |
| Atrazine + mesotrione (50.0 + 500.0) | Calaris® | SC | 2400.0 | Syngenta Proteção de Cultivos Ltda. (Paulínia, São Paulo, Brazil) |
| Mycoinsecticides | ||||
| Beauveria bassiana (Simbi BB15 isolate) | FlyControl® | OD | 500.0 | Simbiose Ltda. (Cruz Alta, Rio Grande do Sul, Brazil) |
| Beauveria bassiana (IBCB 66 isolate) | Bovenat® | WP | 500.0 | Bionat Soluções Biológicas Ltda. (Olímpia, São Paulo, Brazil) |
| Cordyceps javanica (Esalq-1296 isolate) | Octane® | SC | 500.0 | Koppert do Brasil Ltda. (Charqueada, São Paulo, Brazil) |
| Synthetic Herbicides | Esalq-1296 | IBCB66 | Simbi BB15 | |||
|---|---|---|---|---|---|---|
| 1.5 h | 3.0 h | 1.5 h | 3.0 h | 1.5 h | 3.0 h | |
| Glyphosate (SL formulation) | 115.00 ± 1.44 dBA | 78.60 ± 2.16 dBB | 305.80 ± 6.50 bAA | 200.00 ± 3.16 dAB | 32.40 ± 1.68 cCA | 10.4 ± 1.15 eCB |
| Glyphosate (WG formulation) | 159.80 ± 5.26 cAA | 32.80 ± 0.95 eAB | 107.20 ± 3.30 eBA | 0.00 ± 0.00 gBB | 0.40 ± 0.21 dCA | 0.00 ± 0.00 gBA |
| Glufosinate–ammonium | 69.80 ± 2.68 fBA | 23.20 ± 1.28 fAB | 115.80 ± 2.59 eAA | 15.80 ± 1.27 fBB | 34.00 ± 2.00 cCA | 19.80 ± 1.65 dABB |
| Atrazine | 198.60 ± 4.37 abAA | 191.40 ± 5.47 bcAA | 138.80 ± 3.13 dBA | 103.80 ± 2.16 eBB | 106.80 ± 1.58 aCA | 53.40 ± 3.13 bCB |
| Tembotrione | 197.80 ± 3.57 abBA | 195.60 ± 4.64 abBA | 300.20 ± 4.20 bcAA | 254.80 ± 4.10 cAB | 71.20 ± 1.30 bCA | 40.20 ± 1.24 cCB |
| Atrazine + simazine | 100.40 ± 2.32 eBA | 84.20 ± 1.42 dBB | 306.20 ± 3.21 bAA | 285.60 ± 3.33 bAB | 65.40 ± 3.37 bCA | 5.00 ± 1.57 fCB |
| Atrazine + mesotrione | 184.20 ± 3.05 bBA | 176.80 ± 3.52 cBA | 282.60 ± 5.27 cAA | 242.00 ± 6.13 cAB | 33.40 ± 1.90 cCA | 15.80 ± 1.53 deCB |
| Negative control (distilled water) | 207.40 ± 3.75 aBA | 210.60 ± 3.57 aBA | 348.20 ± 2.81 aAA | 342.20 ± 2.87 aAA | 109.00 ± 3.05 aCA | 106.40 ± 2.12 aCA |
| Herbicides (F = 2129.22; Df = 7, 192; p < 0.0001) | ||||||
| Isolates (F = 9529.18; Df = 2, 192; p < 0.0001) | ||||||
| Exposure times (F = 2298.12; Df = 2, 192; p < 0.0001) | ||||||
| Interaction between herbicides × isolates (F = 491.94; Df = 14, 192; p < 0.0001) | ||||||
| Interaction between herbicides × exposure times (F = 158.04; Df = 7, 192; p < 0.0001) | ||||||
| Interaction between isolates × exposure times (F =74.25; Df = 2, 192; p < 0.0001) | ||||||
| Interaction between herbicides × isolates × exposure times (F = 98.18; Df = 14, 192; p < 0.0001) | ||||||
| Synthetic Herbicides | Colony Diameter (mm) 1 | ||
|---|---|---|---|
| Esalq-1296 | IBCB66 | Simbi BB15 | |
| Glyphosate (SL formulation) | 0.00 ± 0.00 eB | 6.93 ± 0.14 dA | 6.59 ± 0.19 eA |
| Glyphosate (WG formulation) | 31.36 ± 0.44 bB | 32.87 ± 0.50 bAB | 33.66 ± 0.39 bA |
| Glufosinate–ammonium | 0.00 ± 0.00 eA | 0.00 ± 0.00 eA | 0.00 ± 0.00 fA |
| Atrazine | 16.74 ± 0.29 dA | 0.00 ± 0.00 eC | 13.59 ± 0.17 dB |
| Tembotrione | 31.78 ± 1.17 bB | 31.35 ± 0.49 bB | 34.33 ± 0.68 bA |
| Atrazine + simazine | 0.00 ± 0.00 eB | 17.29 ± 0.28 cA | 16.87 ± 0.30 cA |
| Atrazine + mesotrione | 27.02 ± 0.71 cB | 32.18 ± 0.22 bA | 32.77 ± 0.52 bA |
| Negative control (distilled water) | 35.79 ± 0.72 aC | 47.25 ± 1.77 aA | 45.05 ± 0.61 aB |
| Herbicides (F = 2043.30; Df = 7, 216; p < 0.0001) | |||
| Isolates (F = 139.97; Df = 2, 216; p < 0.0001) | |||
| Interaction between herbicides × isolates (F = 74.23; Df = 14, 216; p < 0.0001) | |||
| Synthetic Herbicides | Number of Conidia (×107) 1 | (χ2; p-Value) | ||
|---|---|---|---|---|
| Esalq-1296 | IBCB66 | Simbi BB15 | ||
| Glyphosate (SL formulation) | - | 0.02 ± 0.005 fA | 0.01 ± 0.004 eA | χ2 = 3.03; Df = 1; p = 0.0816 |
| Glyphosate (WG formulation) | 70.30 ± 2.96 aA | 9.48 ± 1.66 dB | 2.68 ± 0.49 cC | χ2 = 12.50; Df = 2; p = 0.0019 |
| Glufosinate–ammonium | - | - | - | - |
| Atrazine | 20.30 ± 1.25 cA | - | 2.21 ± 0.21 cB | χ2 = 6.81; Df = 1; p = 0.0090 |
| Tembotrione | 35.50 ± 4.26 bA | 48.20 ± 3.30 cA | 20.60 ± 1.94 aB | χ2 = 9.57; Df = 2; p = 0.0083 |
| Atrazine + simazine | - | 0.39 ± 0.03 eB | 0.90 ± 0.07 dA | χ2 = 6.82; Df = 1; p = 0.0090 |
| Atrazine + mesotrione | 17.90 ± 3.61 cB | 121.89 ± 16.00 bA | 6.60 ± 0.97 bC | χ2 = 10.82; Df = 2; p = 0.0044 |
| Negative control (distilled water) | 81.20 ± 5.25 aB | 319.50 ± 31.20 aA | 23.00 ± 2.67 aC | χ2 = 12.50; Df = 2; p = 0.0019 |
| χ2 | 19.63 | 28.24 | 32.00 | |
| Df | 4 | 5 | 6 | |
| p-value | <0.0001 | <0.0001 | <0.0001 | |
| Synthetic Herbicides | Conidial Germination (%) 1 | (χ2; Df; p-Value) | ||
|---|---|---|---|---|
| Esalq-1296 | IBCB66 | Simbi BB15 | ||
| Glyphosate (SL formulation) | - | - | - | - |
| Glyphosate (WG formulation) | 47.40 ± 0.84 cB | 96.80 ± 0.72 aA | 94.10 ± 0.99 bA | χ2 = 10.67; Df = 2; p = 0.0048 |
| Glufosinate–ammonium | - | - | - | - |
| Atrazine | 19.30 ± 1.00 dA | - | 19.70 ± 1.52 eA | χ2 = 0.04; Df = 1; p = 0.8340 |
| Tembotrione | 67.50 ± 1.37 bC | 76.10 ± 3.05 bB | 86.30 ± 1.29 cA | χ2 = 9.74; Df = 2; p = 0.0076 |
| Atrazine + simazine | - | 3.50 ± 0.61 cB | 26.30 ± 2.18 dA | χ2 = 6.86; Df = 1; p = 0.0088 |
| Atrazine + mesotrione | 64.60 ± 1.63 bC | 84.50 ± 1.70 bB | 89.30 ± 1.25 cA | χ2 = 10.85; Df = 2; p = 0.0044 |
| Negative control (distilled water) | 97.20 ± 0.46 aA | 97.50 ± 0.50 aA | 98.70 ± 0.48 aA | χ2 = 3.60; Df = 2; p = 0.1652 |
| χ2 | 22.23 | 21.41 | 26.83 | |
| Df | 4 | 4 | 5 | |
| p-value | <0.0001 | <0.0001 | <0.0001 | |
| Synthetic Herbicides | Commercial Brands | Toxicity Classification | |||||
|---|---|---|---|---|---|---|---|
| Esalq-1296 | IBCB 66 | Simbi BB15 | |||||
| BI 1 | Classification 2 | BI 1 | Classification 2 | BI 1 | Classification 2 | ||
| Glyphosate (SL formulation) | Roundup Original Mais® | 0.00 | Incompatible | 6.87 | Incompatible | 6.77 | Incompatible |
| Glyphosate (WG formulation) | Roundup WG® | 82.82 | Compatible | 44.36 | Moderately compatible | 49.53 | Moderately compatible |
| Glufosinate–ammonium | Finale® | 0.00 | Incompatible | 0.00 | Incompatible | 0.00 | Incompatible |
| Atrazine | Primóleo® | 33.58 | Incompatible | 0.00 | Incompatible | 20.68 | Incompatible |
| Tembotrione | Soberan® | 68.11 | Compatible | 46.58 | Moderately compatible | 80.46 | Compatible |
| Atrazine + simazine | Primatop SC® | 0.00 | Incompatible | 17.77 | Incompatible | 22.28 | Incompatible |
| Atrazine + mesotrione | Calaris® | 50.09 | Moderately compatible | 57.78 | Moderately compatible | 54.83 | Moderately compatible |
| Commercial Brands | pH | EC (µS/cm) | ho | fl | sd | ps | pg | os | cf | cr | fo | pg * |
|---|---|---|---|---|---|---|---|---|---|---|---|---|
| Synthetic Herbicides | ||||||||||||
| Glyphosate (SL formulation) | 6.42 | 16.98 | P | A | A | A | A | A | A | A | A | A |
| Glyphosate (WG formulation) | 3.56 | 9.91 | P | A | A | A | A | A | A | A | A | A |
| Glufosinate–ammonium | 6.30 | 1824.00 | P | A | A | A | A | A | A | A | A | A |
| Atrazine | 6.98 | 96.00 | P | A | A | A | A | A | A | A | A | A |
| Tembotrione | 3.63 | 59.50 | P | A | A | A | A | A | A | A | A | A |
| Atrazine + simazine | 6.76 | 336.00 | P | A | A | A | A | A | A | A | A | A |
| Atrazine + mesotrione | 3.14 | 325.00 | P | A | A | A | A | A | A | A | A | A |
| Mycoinsecticides | ||||||||||||
| FlyControl® | 5.39 | 6.58 | P | A | A | A | A | A | A | A | A | A |
| Bovenat® | 5.48 | 9.09 | P | A | A | A | A | A | A | A | A | A |
| Octane® | 5.50 | 8.09 | P | A | A | A | A | A | A | A | A | A |
| Water | 5.40 | 3.95 | - | - | - | - | - | - | - | - | - | - |
| Synthetic herbicides + mycoinsecticides | ||||||||||||
| Glyphosate (SL formulation) + FlyControl® | 6.41 | 17.02 | A | A | A | P | A | A | A | A | A | A |
| Glyphosate (WG formulation) + FlyControl® | 3.59 | 9.87 | A | A | A | P | A | A | A | A | A | A |
| Glufosinate–ammonium + FlyControl® | 6.28 | 1819.00 | A | A | A | P | A | A | A | A | P | A |
| Atrazine + FlyControl® | 6.95 | 99.00 | A | A | A | P | A | A | A | A | A | A |
| Tembotrione + FlyControl® | 3.72 | 56.70 | A | A | A | P | A | A | A | A | A | A |
| Atrazine + simazine + FlyControl® | 6.80 | 328.00 | A | A | A | P | A | A | A | A | A | A |
| Atrazine + mesotrione + FlyControl® | 3.30 | 321.00 | A | A | A | P | A | A | A | A | A | A |
| Glyphosate (formulation SL) + Octane® | 6.42 | 16.73 | P | A | A | A | A | A | A | A | A | A |
| Glyphosate (formulation WG) + Octane® | 3.70 | 9.66 | P | A | A | A | A | A | A | A | A | A |
| Glufosinate–ammonium + Octane® | 6.43 | 1726.00 | P | A | A | A | A | A | A | A | P | A |
| Atrazine + Octane® | 7.03 | 101.00 | P | A | A | A | A | A | A | A | A | A |
| Tembotrione + Octane® | 3.69 | 58.80 | P | A | A | A | A | A | A | A | A | A |
| Atrazine + simazine + Octane® | 6.86 | 335.00 | P | A | A | A | A | A | A | A | A | A |
| Atrazine + mesotrione + Octane® | 3.20 | 327.00 | P | A | A | A | A | A | A | A | A | A |
| Glyphosate (SL formulation) + Bovenat® | 6.41 | 15.19 | P | A | A | A | A | A | A | A | A | A |
| Glyphosate (WG formulation) + Bovenat® | 3.66 | 10.14 | P | A | A | A | A | A | A | A | A | A |
| Glufosinate–ammonium + Bovenat® | 6.36 | 1752.00 | P | A | A | A | A | A | A | A | P | A |
| Atrazine + Bovenat® | 6.96 | 93.90 | P | A | A | A | A | A | A | A | A | A |
| Tembotrione + Bovenat® | 3.96 | 93.30 | P | A | A | A | A | A | A | A | A | A |
| Atrazine + simazine + Bovenat® | 6.71 | 283.40 | P | A | A | A | A | A | A | A | A | A |
| Atrazine + mesotrione + Bovenat® | 3.26 | 304.00 | P | A | A | A | A | A | A | A | A | A |
| Synthetic Herbicides | Octane® | FlyControl® | ||
|---|---|---|---|---|
| 1.5 h | 3 h | 1.5 h | 3 h | |
| Glyphosate (SL formulation) | 14.40 ± 0.67 eBA | 0.00 ± 0.00 fBB | 515.60 ± 8.77 bAA | 299.40 ± 7.17 cAB |
| Glyphosate (WG formulation) | 1.20 ± 0.52 fBA | 0.00 ± 0.00 fAB | 158.60 ± 6.48 fAA | 0.00 ± 0.00 fAB |
| Glufosinate–ammonium | 319.20 ± 2.96 cBA | 269.80 ± 3.67 dBB | 543.80 ± 9.84 bAA | 292.40 ± 7.27 cAB |
| Atrazine | 976.60 ± 5.79 aAA | 836.80 ± 5.56 bAB | 283.80 ± 5.50 dBA | 278.40 ± 7.44 cBA |
| Tembotrione | 57.40 ± 1.34 dBA | 57.60 ± 1.97 eBA | 338.40 ± 8.62 cAA | 226.40 ± 5.89 dAB |
| Atrazine + simazine | 669.40 ± 4.53 bAA | 480.20 ± 3.70 cAB | 367.20 ± 6.66 cBA | 348.80 ± 7.37 bBA |
| Atrazine + mesotrione | 62.00 ± 1.88 dBA | 46.20 ± 1.63 eBB | 197.00 ± 5.99 eAA | 62.40 ± 4.08 eAB |
| Negative control (distilled water) | 997.20 ± 5.98 aAA | 995.60 ± 6.76 aAA | 592.80 ± 12.75 aBA | 592.60 ± 11.25 aBA |
| Herbicides (F = 7468.17; Df = 7, 128; p < 0.0001) | ||||
| Mycoinsecticides (F = 690.44; Df = 1, 128; p < 0.0001) | ||||
| Exposure times (F = 1937.33; Df = 1, 128; p < 0.0001) | ||||
| Interaction between herbicides × mycoinsecticides (F = 2703.91; Df = 7, 128; p < 0.0001) | ||||
| Interaction between herbicides × exposure times (F = 122.98; Df = 7, 128; p < 0.0001) | ||||
| Interaction between mycoinsecticides × exposure times (F = 371.25; Df = 1, 128; p < 0.0001) | ||||
| Interaction between herbicides × mycoinsecticides × exposure times (F = 157.53; Df = 7, 128; p < 0.0001) | ||||
| Synthetic Herbicides | Esalq-1296 | Octane® | Simbi BB15 | FlyControl® | ||||
|---|---|---|---|---|---|---|---|---|
| 1.5 h | 3 h | 1.5 h | 3 h | 1.5 h | 3 h | 1.5 h | 3 h | |
| Glyphosate (SL formulation) | 44.55 | 62.68 | 98.55 | 100.00 | 70.28 | 90.23 | 12.87 | 49.30 |
| Glyphosate (WG formulation) | 22.95 | 84.43 | 99.88 | 100.00 | 99.63 | 100.00 | 73.19 | 100.00 |
| Glufosinate–ammonium | 66.35 | 88.98 | 67.99 | 72.90 | 68.81 | 81.39 | 8.14 | 50.46 |
| Atrazine | 4.24 | 9.12 | 2.05 | 15.92 | 2.02 | 49.81 | 51.99 | 51.97 |
| Tembotrione | 4.63 | 7.12 | 94.24 | 94.21 | 34.68 | 62.22 | 42.69 | 61.80 |
| Atrazine + simazine | 51.59 | 60.02 | 32.87 | 51.76 | 40.00 | 95.30 | 37.87 | 40.96 |
| Atrazine + mesotrione | 11.19 | 16.05 | 93.78 | 95.35 | 69.36 | 85.15 | 66.68 | 89.46 |
| Treatment | % Mortality 1 | % Extrusion 3 | Number of Conidia (×107) 2 |
|---|---|---|---|
| Glyphosate (SL formulation) | 32.00 ± 5.21 bcde | 0.00 | - |
| Glyphosate (WG formulation) | 14.00 ± 3.57 efghi | 0.00 | - |
| Glufosinate–ammonium | 16.00 ± 2.19 defghi | 0.00 | - |
| Atrazine | 14.00 ± 6.69 efghi | 0.00 | - |
| Tembotrione | 4.00 ± 2.19 hi | 0.00 | - |
| Atrazine + simazine | 8.00 ± 1.78 ghi | 0.00 | - |
| Atrazine + mesotrione | 4.00 ± 2.19 hi | 0.00 | - |
| Glyphosate (SL formulation) + Octane® | 34.00 ± 6.69 bcd | 0.00 | - |
| Glyphosate (WG formulation) + Octane® | 14.00 ± 6.06 efghi | 0.00 | - |
| Glufosinate–ammonium + Octane® | 52.00 ± 10.73 ab | 0.00 | - |
| Atrazine + Octane® | 28.00 ± 5.93 cdef | 0.00 | - |
| Tembotrione + Octane® | 14.00 ± 3.57 efghi | 0.00 | - |
| Atrazine + simazine + Octane® | 10.00 ± 5.65 fghi | 0.00 | - |
| Atrazine + mesotrione + Octane® | 10.00 ± 2.82 fghi | 0.00 | - |
| Glyphosate (SL formulation) + FlyControl® | 58.00 ± 10.73 a | 0.00 | - |
| Glyphosate (WG formulation) + FlyControl® | 48.00 ± 5.21 abc | 0.00 | - |
| Glufosinate–ammonium + FlyControl® | 52.00 ± 7.69 ab | 0.00 | - |
| Atrazine + FlyControl® | 26.00 ± 6.69 cdef | 0.00 | - |
| Tembotrione + FlyControl® | 14.00 ± 2.19 efghi | 0.00 | - |
| Atrazine + simazine + FlyControl® | 28.00 ± 7.69 cdef | 0.00 | - |
| Atrazine + mesotrione + FlyControl® | 20.00 ± 6.92 defgh | 0.00 | - |
| C. javanica Esalq-1296 (Octane®) | 24.00 ± 6.69 defg | 25.00 | 1.34 ± 0.07 a |
| B. bassiana Simbi BB 15 (FlyControl®) | 18.00 ± 8.19 defghi | 33.30 | 0.74 ± 0.05 b |
| Bifenthrin + carbosulfan | 100.00 ± 0.00 * | 0.00 | - |
| Negative control (distilled water) | 2.00 ± 1.78 i | 0.00 | - |
| F | 5.52 | - | 33.75 |
| Df | 23, 96 | - | 1, 4 |
| p | <0.0001 | - | =0.0043 |
Disclaimer/Publisher’s Note: The statements, opinions and data contained in all publications are solely those of the individual author(s) and contributor(s) and not of MDPI and/or the editor(s). MDPI and/or the editor(s) disclaim responsibility for any injury to people or property resulting from any ideas, methods, instructions or products referred to in the content. |
© 2024 by the authors. Licensee MDPI, Basel, Switzerland. This article is an open access article distributed under the terms and conditions of the Creative Commons Attribution (CC BY) license (https://creativecommons.org/licenses/by/4.0/).
Share and Cite
Rakes, M.; Morais, M.C.; Sperotto, M.E.; Zanardi, O.Z.; Bernardi, D.; Grützmacher, A.D.; Ribeiro, L.d.P. Toxicity of Post-Emergent Herbicides on Entomopathogenic Fungi Used in the Management of Corn Leafhopper: In Vitro and In Vivo Assessments. Agriculture 2024, 14, 2189. https://doi.org/10.3390/agriculture14122189
Rakes M, Morais MC, Sperotto ME, Zanardi OZ, Bernardi D, Grützmacher AD, Ribeiro LdP. Toxicity of Post-Emergent Herbicides on Entomopathogenic Fungi Used in the Management of Corn Leafhopper: In Vitro and In Vivo Assessments. Agriculture. 2024; 14(12):2189. https://doi.org/10.3390/agriculture14122189
Chicago/Turabian StyleRakes, Matheus, Maíra Chagas Morais, Maria Eduarda Sperotto, Odimar Zanuzo Zanardi, Daniel Bernardi, Anderson Dionei Grützmacher, and Leandro do Prado Ribeiro. 2024. "Toxicity of Post-Emergent Herbicides on Entomopathogenic Fungi Used in the Management of Corn Leafhopper: In Vitro and In Vivo Assessments" Agriculture 14, no. 12: 2189. https://doi.org/10.3390/agriculture14122189
APA StyleRakes, M., Morais, M. C., Sperotto, M. E., Zanardi, O. Z., Bernardi, D., Grützmacher, A. D., & Ribeiro, L. d. P. (2024). Toxicity of Post-Emergent Herbicides on Entomopathogenic Fungi Used in the Management of Corn Leafhopper: In Vitro and In Vivo Assessments. Agriculture, 14(12), 2189. https://doi.org/10.3390/agriculture14122189

